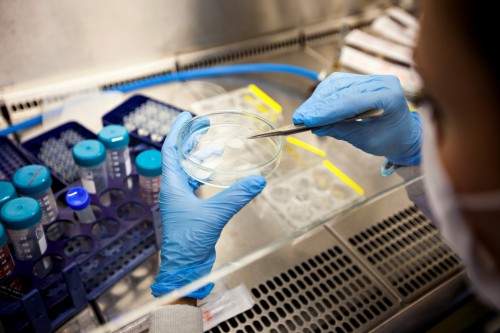
诺维信旗下益生菌爱弗乐，珍弗乐登陆中国助力国内益生菌市场发展

2020年12月24日,爱尔兰益生菌领导品牌Precision Biotics®宣布其跨境电商旗舰店在天猫国际正式上线。

以匠心打造精准、独特的益生菌品牌
PrecisionBiotics®是源自爱尔兰的优秀益生菌品牌,以天然、精准、科学为研发理念,致力于开发自然界优秀的、创新型益生菌菌株,通过天然方式帮助消费者解决健康困扰。自2000年成立以来,品牌已经积累了超过20年的研发经验,在菌种鉴定、基因表达、精准筛选等方面经验丰富且获得业内高度认可;已实现多株菌株分离,并在消费品和医疗产品中商业化应用;品牌发展始终以科学为依据,通过对菌株的精准筛选、精准培养及精准配方,提供天然的健康解决方案。

以科学为基石,以创新为引领,甄选好菌开启健康生活
中国已成为全球益生菌产品增长最快的市场,行业高速发展的背后,产品也日趋多样化。作为益生菌行业优秀品牌,PrecisionBiotics®将全球益生菌市场发展特点与中国消费者洞察紧密结合,将两款明星产品引入中国,为中国益生菌市场引入活力及更加多样化的产品选择。调研表明,随着消费者对益生菌产品的接受度及认可度不断提高,逐渐出现差异化需求,独特功效的产品成为市场追逐的热点;同时消费者也日趋理性,能够科学论证产品功效、提供有效的临床试验数据,是高品质产品的基本要求。
王牌产品“珍爱组合”,缓解焦虑、增强活力,和压力Say Bye-bye
此次进入中国的两款益生菌产品分别为珍弗乐® (Zenflore®)和爱弗乐®(Alflorex®)。珍弗乐®所含菌株为长双歧杆菌1714-Serenitas®,主打缓解焦虑、促进睡眠、增强活力功效。对一个久在喧嚣都市的人来说,如何能在快节奏的生活中更好的应对各项挑战、缓解压力导致的焦虑情绪、从容应对学业、工作、生活中的各项突发事件,以更轻松、富有活力的方式开始美好的一天,是80后、90后乃至00后都需要面对的问题。临床试验证实,珍弗乐®通过肠脑轴作用,激活迷走神经、抑制皮质醇分泌等方式,调节压力下的神经反应,从而帮助更好的应对压力并减少精神疲劳。即日起,中国的消费者上淘宝搜索爱弗乐或者珍弗乐就能购买到源自爱尔兰的专业益生菌,享受到欧洲优质的生活品质。

爱弗乐所含菌株为长双歧杆菌35624® ,有效改善肠道环境,让肠道充满活力,为健康助力。经过临床试验和消费者双重认证:有效迅速缓和腹痛、腹泻、便秘、胀气等症状;经过临床试验测试,成为美国胃肠病医生首选推荐的益生菌产品,在美国、加拿大、欧洲及爱尔兰市场获得消费者高度认可及好评;口碑极佳,>60%的消费者会按月复购。

适合于儿童,能够建立稳定的肠胃环境,平衡菌群,适合患有消化疾病的儿童,缓解腹泻、便秘、气胀、腹痛等症状;适用于肠易激综合症(IBS)患者, 35624®菌株能够锁定受刺激的肠壁,以提供镇定和增强屏障功效,从而抵抗IBS中发生的肠屏障功能受损,并减轻IBS所产生的腹胀、腹痛及腹泻和便秘的症状。已经在法国、波兰、乌克兰、俄罗斯等国的肠易激综合症治疗指南中被引用。
万物浩瀚 · 追求唯一,诺维信与香港维健医药集团深度合作,强势发力益生菌业务

诺维信是丹麦在华最大投资企业之一,是全球工业酶制剂和微生物制剂的优秀企业,在全球拥有>40%的市场份额,为全球市场提供创新性解决方案。2001年,诺维信从丹麦制药公司诺和诺德公司分离,到2019年,全球销售收入达到147亿元,业务遍及130个国家。诺维信全球拥有6000 名员工,从事研发、生产、销售和行政工作。诺维信公司已在丹麦哥本哈根证券交易所上市(股票代码NZYM B)。

自1997年进入中国以来,诺维信在华创立了首家外资生物技术企业的研发中心。坐落于北京中关村科技园内的诺维信中国区总部,拥有占地5000平方米的现代化实验室。研发人员应用传统微生物学、现代生物化学、分子生物学、生物信息学等领域的多项先进核心技术,包括表达克隆、重组技术、蛋白工程和高通量筛选技术等。
2019年,诺维信成立人类健康业务品牌OneHealth,以诺维信强大的生物技术和杰出的研发能力为后盾,以消费者洞察及数据分析为基础,在诺维信 “重塑未来” 战略使命的驱动下,勇于尝试、大胆创新,致力于打造人类健康的新未来。2020年6月,诺维信OneHealth以8000万欧元的价格收购爱尔兰益生菌公司PrecisionBiotics(简称PBG),进一步加强双方在益生菌研发领域的技术优势。
香港维健医药集团有限公司是一家设立于香港、面向中国大陆的创新医药公司,通过致力于引进和商业化专利来满足大中华区市场的庞大医疗需求缺口,共分为成熟药品事业部(EPD)和以罕见病为中心的创新药品事业部(ITD)两大板块,其中成熟药品事业部涵盖呼吸系统疾病和抗感染、心血管疾病、消化与肝病、皮肤与医美、泌尿系统疾病等领域。通过为国际知名医药企业提供本地研发、注册和商业化的一体化服务,维健医药已成为中国知名的CDCO(合同开发和商业化组织)集团之一,客户中包括多家世界排名500强跨国制药企业。公司总部设在中国香港,在杭州、上海、北京、广州、海南、东京和慕尼黑设有运营中心和办事处。
香港维健医药全球运营网络

此次签约,标志着双方建立了长期、稳固的战略合作伙伴关系,未来也将不断创新合作模式,探索更广阔的全球合作前景,双方将一如既往地凭借自身在行业内的专业影响力推动Precision Biotics®在中国健康领域的持续发展,为中国的健康事业贡献积极的力量。